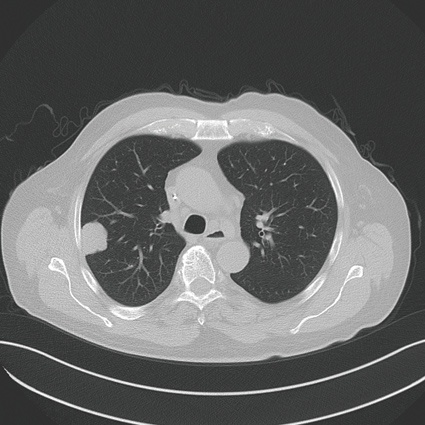
Lungenmetastase bei Z.n. Rektumkarzinom, minimalinvasive Ablation mittels...

Mikrowellenablation zur Therapie von malignen Tumoren der Lunge

Das neue Gebiet der interventionellen Onkologie fasst Therapieverfahren zusammen, die auf dem interventionell bildgebend gesteuerten Einsatz moderner Therapieverfahren beruhen.
Die Behandlung von malignen Lungentumoren, sowohl dem primären Lungenkarzinom wie auch von Lungenmetastasen, stellt eine große Herausforderung an die Onkologie dar. Auch erweisen sich die herkömmlichen Therapieverfahren wie operative Resektion, die Radiatio und verschiedene Verfahren der Chemotherapie sowie Immuntherapie häufig als limitiert.
Das neue Gebiet der interventionellen Onkologie fasst Therapieverfahren zusammen, die auf dem interventionell bildgebend gesteuerten Einsatz modernen Therapieverfahren beruhen. Darunter gehören Thermoablationsverfahren wie die Lasertherapie (LITT), die Mikrowellenablation (MWA) und die Radiofrequenzablation (RFA). Ergänzt wird das Teilgebiet der interventionellen Onkologie durch Therapieverfahren wie regionale Chemotherapie und Embolisation, dies erfolgt einmal über das Lungengefäßsystem der Vasa privata, über die Bronchialarterien als Bronchialarterienembolisation und auch als Chemoembolisation über das Versorgungsgebiet der pulmonalen Arterien in Form einer pulmonalarteriellen Chemotherapie mit Perfusion, Okklusion und Embolisation (TPCE).
Die Frage der Effizienz minimalinvasiver Therapieverfahren zur Therapie von isolierten Lungenläsionen muss folgende Punkte berücksichtigen:
- Optimiertes technisches Verfahren
- Vergleichende Bewertung Radiofrequenzverfahren versus Mikrowellen-ablation, versus Laserablation
- Optimierte lokale Therapiekontrolle: Vollständige Ablation (A0-Ablation)
- Möglichst geringe Komplikations- und Nebenwirkungsrate
- Einbindung des interventionellen Therapieverfahrens in ein onkologisches Tumorkonzept
Das neue Verfahren der Mikrowellenablation stellt insgesamt eine Weiterführung der bisherigen Therapiestrategien basierend auf der monopolaren oder bipolaren Radiofrequenztherapie (RFA) dar. Der Vorteil der Mikrowellenablation liegt dabei in der schnelleren Durchführbarkeit, der höheren Effizienz und den fehlenden Limitationen der physikalischen Energieausbreitung wie bei der RFA. Daraus resultiert ein insgesamt höheres Ablationsvolumen und eine verbesserte Therapiekontrolle.
Die Indikationsstellung umfasst derzeit für die percutane Thermoablation mittels Mikrowellenablation Patienten, die nicht mehr resektabel sind, Patienten, die durch die Intervention in eine resektable Situation überführt werden können, die Anzahl der Herde sollte dabei eine Zahl von ≤ 3 nicht überschreiten, die Größe der Herde ≤ 3 max. 4 cm.
Zielsetzung der Mikrowellenablation (und weiteren Ablationstechniken) ist die komplette Destruktion aller vitalen Tumorzellen im Zielvolumen mit einem Sicherheitssaum, Minimierung der Schädigung von Umgebungsstrukturen. Die möglichen Vorteile gegenüber einem chirurgischen Verfahren liegen in der hohen Ortspräzision und dem selektiven Zugangsweg und einer minimal-invasiven Behandlungsstrategie mit tagesstationärer Durchführbarkeit und einer geringeren Belastung des umgebenden normalen Lungenparenchyms. Die Grundlage der Therapie ist dabei die Erzielung einer Temperaturerhöhung intratumoral und in den Sicherheitszonen zwischen 80 und 100 Grad Celsius und geht in der Regel einher mit einer kompletten Destruktion von Zellanteilen wie den Mitrochondrien im Zytoplasma und weiteren Leitstrukturen.
Die Ergebnisse der Lungenablation mittels Mikrowelle können dabei basierend in drei wesentlichen Arbeiten nachgewiesen werden.
Die Arbeit von Wolf 2008 beinhaltete 50 Patienten mit primärem Bronchialkarzinom, 20 mit Metastasen, die lokale Tumorkontrollrate lag bei 74 % bei 10 Monaten follow-up, die Überlebensraten von 1 Jahr bei 65 %, 2 Jahre bei 50 %, 3 Jahre bei 45 %.
In unserer Untersuchungsreihe wurden 80 Patienten therapiert mit 130 Metastasen, die lokale Tumorkontrollrate lag bei einem mittleren Follow-up von 16 Monaten bei 71,1 %, die 2-Jahre-Überlebensdaten waren bei 91,3 % und 75 %.
Die besten Daten bezüglich der Ortskontrolle zeigten Lungenmetastasen ≤ 3 cm mit einer möglichst peripheren Lage der Herde.
Zusammenfassend stellt die Mikrowellenablation von primären Lungentumoren (NSCLC) und Lungenmetastasen eine vielversprechende neue Therapietechnik dar bei hoher Effizienz und guten lokalen Ortskontrolldaten im Vergleich zu den bisherigen Verfahren der Radiofrequenzablation und der laserinduzierten Thermotherapie. Insbesondere die Lage eines Herdes und die Größe vor der Ablation bestimmen dabei die lokalen Tumorkontrollergebnisse. Eine Tumorgröße von mehr als 3 cm erweist sich für die thermische Ablation als problematisch. Weitere prospektive Arbeiten müssen sich mit dem Thema der Thermoablation und Korrelation zu chirurgischen Strategien, aber auch anderen Ablationsverfahren auseinandersetzen.
Meist gelesen

Pro Care 2026 zeigt innovative Versorgungslösungen aus der Hauswirtschaft
Pflegequalität entsteht nicht nur am Pflegebett, sondern in allen Bereichen des Alltags, die das Leben in einer Einrichtung prägen.

Kostenoptimierung und Förderung strategischer Beschaffung
Kostensenkungen und kurzfristige Kürzungen können die Flexibilität, die Leistung und die strategische Ausrichtung eines Unternehmens beeinträchtigen.

Elektronische Zutrittskontrolle von Winkhaus erleichtert NIS-2-Konformität
Die NIS-2-Richtlinie fordert eine zuverlässige Zutrittskontrolle für kritische Infrastrukturen. Das Schließsystem blueEvo erfüllt diese Anforderungen.

Slipeinlagen beugen bakterieller Vaginose vor
Weltweit hat knapp ein Drittel der Frauen in der fruchtbaren Lebensphase eine bakterielle Vaginose. Dabei kommt das empfindliche Mikrobiom der Vagina aus dem Gleichgewicht.

Ein Brief an die Zukunft: Stefan Drägers Vision vom Krankenhaus der Zukunft
Stefan Drägers Brief an das Krankenhaus der Zukunft und über die Vision seiner Familie.





